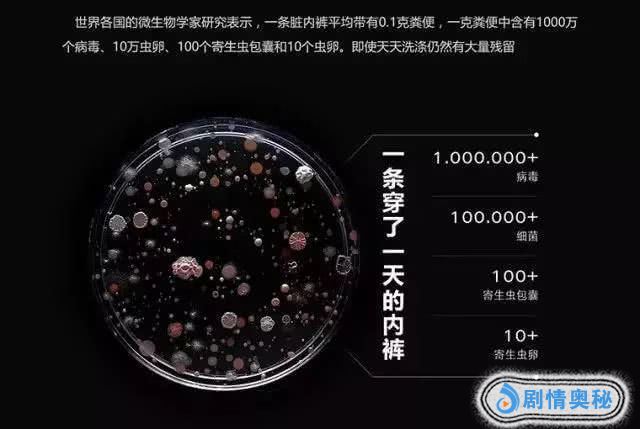

身材,永远是女生的头等大事,不管什么时候都不能松懈。今天小编就推荐一款量子收腹裤,让你穿上就显瘦10斤,拥有维密超模同款小蛮腰、蜜桃臀!

一到冬天,虽然大家外面都穿得厚实,但脱了外套,胖胖的你就藏不住腰腹的“游泳圈”,还有横看竖看都是又大又平的肥屁股,真的是太辣眼睛了!

每次都是嘴上说着减肥,但真正有效减肥谈何容易!平常上班一整天就足够累了,私下根本没有时间和毅力跑健身房,完全迈不开腿,当然瘦不下来。

再加上平时聚餐活动又管不住嘴,特别是现在天气冷,热乎乎的烧烤、火锅、麻辣烫每次都吃到撑,结果冬天还没过完,腰又粗了一圈!

还有想着利用减肥药瘦身的朋友,效果暂且不论,安全性倒是值得着重考虑,“是药三分毒”啊,万一伤到身体就不划算了。
折腾了半天,肉肉依旧没减。眼看着年关将近,难道自己要带着这一身赘肉过年回家参加同学会、见亲戚,甚至是见情敌吗?

虽然减肥已经来不及,但是想在年前收住小肚子,还是可以的!近年来,很多聪明的女生都选择了“收腹裤”来塑形瘦身。
你只需一条巨显瘦巨舒服的NanoJ科技芯片塑形收腹裤,上面的问题全都能完美解决啦!
CK御用工厂出品
大牌品质,高性价比
论舒适好穿的内裤,10个人,9个人都会推荐CK。据说CK的内裤,穿过都说舒服。
不过,CK作为美国第一大设计师品牌,随便一款内衣裤都在600元以上!吃土少女表示买一件就要肉疼一个月!再喜欢也舍不得入手!

但是现在CK的大牌品质,只需要100多元就能买到了!因为NanoJ这款科技芯片塑形收腹裤,就是CK御用工厂出品的,性价比简直不要太高!
不仅如此,NanoJ的设计团队还获得了意大利 A'Design Award 国际设计奖金奖,意大利女生都称他们家的产品是“女生的福音”!

这个款式,NanoJ为大家准备了黑色、浅灰、藕粉、肤色四款经典百搭的颜色。

四个颜色难以取舍,小编就全买了,穿了几个月,明显感觉肚子上的肉肉变得紧实,腰身也变细了,旧裤子穿起来居然都大了一圈,而且这款收腹裤还非常柔软有弹力,晚上穿着睡觉很舒服。

1秒收腹提臀
轻压塑形不勒肉
传统的收腹裤,对于很多女生来说简直就是噩梦。
因为它们虽然有收腹效果,但是每次穿脱都要使出吃奶的劲,而且是简单粗暴把肉勒到一起,闷热不透气,分分钟感觉要窒息。

和传统的收腹裤不同,NanoJ是小编穿过最舒服的收腹裤,因为它并不是通过野蛮的挤压来瘦身的,穿脱轻松,没有一点压迫感。
NanoJ收腹裤主张轻压塑形,从臀部到腰部,逐渐收紧的设计,分段式压力作用于身体,该瘦的地方帮你瘦,该凸的地方帮你放松。

腰腹部采用高密度针织,给腰腹部一个微压的力,结合超高腰的版型设计,轻轻一拉就能拉到胸围下面,立马收紧腰腹的赘肉,提拉臀部线条,轻松不勒肉。

不管是肥胖女生还是产后妈妈,它都能1秒收起大肚腩,腰围小3圈!以前穿不上的衣服,现在可以随便穿!

小编还拿给办公室的其他小姐姐试穿,穿上后腰围居然立减14cm,赶紧也入手了其他颜色的,还说要安利给闺蜜呢!

动态对比一看,这收腰的效果简直不要太明显!腰腹平坦,体态看上去更轻盈,浑身上下都透着少女感!

3D立体臀设计
穿出性感小翘臀
更让小编惊喜的是NanoJ这款收腹裤,不但能让你瘦腰,还能帮你提臀。
特别在臀部添加性感3D立体桃心臀杯,360°贴合臀部,包裹臀部脂肪,一穿即显圆润臀峰。

同时加大臀侧两边的针织密度,利用向心力上托提臀,提拉下垂臀部,收紧臀部赘肉。

这样一来,扁平大肥臀立马变成Q弹蜜桃臀!长期坚持穿着还能保持S型的完美曲线,别人举铁深蹲一年都未必练得出,现在用一条收腹裤就全解决!

一片式无缝裸氨面料
轻薄透气更健康
另外值得一提的是它的面料,NanoJ采用的是一片式无缝裸氨面料,直接一根氨纶织入,比起一般的包纱氨纶的工艺要求更高。

同时NanoJ还采用一体成型的无缝技术编织,32针裸氨织造制成的内裤:更轻薄、更透气、更柔软!弹力更强!回弹性更高!

刚拿到手的时候,小编就被它的质感打动,亲肤度简直能媲美蚕丝内裤,穿在身上一点都不扎,触感就像贴身敷丝质面膜。

小编还特别称了一下,没想到整条内裤只有79克重,可以说非常轻薄了,上身甚至感觉不到它的存在,上课、上班、逛街毫无压力,轻盈舒适到不想脱!

而且它的透气性比纯棉的还要好,哪怕冬天捂得严严实实,也能够随时吸收腰腹的汗水,并快速排出体外,无论怎么穿都不会有任何闷湿的感觉。

另外,裸氨面料的弹力也是相当惊人!亲水性弹力金属和透气面料融为一体,完美回弹不走形,又能满足女生各种身材需求。

科技量子芯片
温宫暖腰,调理身体
俗话说:十女九寒。其实很大一部分原因是我们穿的内裤不对。
女生通常穿的低腰内裤无法保护腹部,经常还会让子宫、胃部处于受寒状态,特别是手脚冰冷的女生更要注意这一点。

而NanoJ这款收腹裤采用超高腰设计,不仅可以收胃收腰,还可以防止寒气进入子宫,从而通过暖宫、调经、养血有效保护身体健康。

更令人惊喜的是这款收腹裤的前侧还增加了3颗科技量子波芯片,作用于三大人体穴位,对应调节人体多种问题。

中脘穴:改善胃痛、消化不良、慢性肝炎、恶心、烧心等。
神阙穴:改善腹泻腹胀、月经不调等。
关元穴:改善虚胖浮肿、月经不调、痛经等。

量子芯片每秒产生上亿次的高频震动波,与人体的频率和谐共振,协调体内的电流平衡,抖落微循环内壁的脂质斑块、毒垢、血栓,清理血管、燃烧脂肪,防止小肚腩的出现。

长期穿着能有效改善微循环,调节内分泌,从外而内温暖子宫,科学调理子宫环境,有效保护女性身体健康和生育能力!
小编穿了一段时间,明显感觉自己排毒祛湿之后,不仅痘痘和小肚腩逐渐改善,整个人的气色也跟着好了起来。

科学剪裁
无缝贴合,拒绝尴尬
虽然现在不是夏天,但小编还是会担心穿紧身裤、包臀裙时暴露内裤痕迹,真的是要多尴尬就有多尴尬。

自从有了NanoJ收腹裤,就完全没有这种担忧了!
因为它采用了人体工学原理设计,再加上精密细致的无缝剪裁技术,整条内裤每一寸都能紧密无缝贴合,穿起来几乎是隐形无痕的,完全不会在外衣上暴露内裤痕迹,杜绝尴尬!

和市面上常见的金属软骨不同,NanoJ收腹裤挑选了全新回弹性记忆鱼骨贯穿其中,材质高档,收腹不紧不扎很安全。
而且非常贴合腰身,不卷边不滑落!哪怕穿个一两年,也能保持收腹力和弹力强劲不变形!

腰部螺纹包边设计,舒适不勒,实用耐穿!

裤口的设计也非常贴心,采用的是小皮筋包边,有一定的弹力伸缩,可以避免太紧勒腿或太松内裤移位,很贴心。

海藻纤维底裆
杀菌抑菌,私处更清爽
对于女生来说,内裤作为第二层肌肤,保护着身体最私密的三角区。
本就终日不见阳光,又吸收大量体液、汗液、尿液,成了病毒、细菌滋生的重灾区。
针对这个问题,NanoJ收腹裤采用了双层裆部设计,多加的这一层海藻纤维底裆,可以有效吸湿透气、安全抑菌,保持私处的清爽舒适。

海藻纤维具有快速吸水性,吸液倍率高达100倍,同时又有良好的抑菌性能,能抑制湿润环境中的细菌滋生。
NanoJ收腹裤用这种纤维做底档,内层抗菌抑菌,外侧遮挡污垢,给私部最安全的贴心保护,有效预防妇科疾病。

另外,这款海藻纤维是由NanoJ科研团队自主研发的卫生护理材料专用技术制备的,经过特殊工艺软化,柔软度和舒适度满分,一点都不会扎人。

四色可供选择
不分季节,一年四季可穿
一共有四色可选,肤色超百搭,黑色更显瘦,藕粉色女人味,灰色很优雅。选择困难症的小编自然是全入了,不管是穿深色还是浅色衣服都很百搭,一年四季都能穿呢!

NanoJ收腹裤采用日本的活性印染技艺,运用纯手工、纯天然植物色素,植物染色更安心,固色效果更佳,色彩更加鲜亮,100℃的清水清洗也完全不掉色,非常绿色健康。

它的耐磨性也经得起考验,不变形、不起球。
不管怎么揉搓,轻轻一抚就能恢复如初,而且用小刀从它身上划过也不见丝毫勾丝!


而且NanoJ这款收腹裤还通过了国家安全检测,质量有保障,穿着更放心!

每条都是独立包装,关键是好看好用还不贵!

NanoJ 收腹裤
瘦身打底 暖宫收腹 抗菌提臀 轻塑形科技芯片
粉丝特惠价:78元/条


















